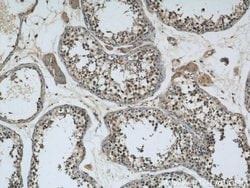

Learn More
GSK3B Rabbit anti-Human, Mouse, Rat, Polyclonal, Proteintech
Rabbit Polyclonal Antibody
136.48 CHF - 385.92 CHF
Spezifikation
| Antigen | GSK3B |
|---|---|
| Konzentration | 0.41 mg/mL |
| Anwendungen | Immunofluorescence, Immunoprecipitation, Western Blot, Immunohistochemistry (Paraffin), Immunocytochemistry |
| Klassifikation | Polyclonal |
| Konjugat | Unconjugated |
| Produktcode | Marke | Menge | Preis | Menge & Verfügbarkeit | |||||
|---|---|---|---|---|---|---|---|---|---|
| Produktcode | Marke | Menge | Preis | Menge & Verfügbarkeit | |||||
|
16881645
|
Proteintech
22104-1-AP-20UL |
20 μL |
136.48 CHF
20 Mikroliter |
Lager vorrätigLoggen Sie sich ein, um den Lagerbestand zu sehen
|
Sie haben bereits ein Konto? Melden Sie sich an um den Preis und die Verfügbarkeit zu sehen. Neu hier? Registrieren Sie sich noch heute bei uns! |
||||
|
16871645
|
Proteintech
22104-1-AP-150UL |
150 μL |
385.92 CHF
150 Mikroliter |
Lager vorrätigLoggen Sie sich ein, um den Lagerbestand zu sehen
|
Sie haben bereits ein Konto? Melden Sie sich an um den Preis und die Verfügbarkeit zu sehen. Neu hier? Registrieren Sie sich noch heute bei uns! |
||||
Beschreibung
This antibody recognize the C-terminal of GSK3B.
Menin is a putative tumor suppressor associated with a syndrome known as multiple endocrine neoplasia type 1. In vitro studies have shown menin is localized to the nucleus, possesses two functional nuclear localization signals, and inhibits transcriptional activation by JunD, however, the function of this protein is not known. Two messages have been detected on northern blots but the larger message has not been characterized. Two variants of the shorter transcript have been identified where alternative splicing affects the CDS. Five variants where alternative splicing takes place in the 5′ UTR have also been identified.Spezifikation
| GSK3B | |
| Immunofluorescence, Immunoprecipitation, Western Blot, Immunohistochemistry (Paraffin), Immunocytochemistry | |
| Unconjugated | |
| Rabbit | |
| Human, Mouse, Rat | |
| P18266, P49841, Q9WV60 | |
| 2932, 56637, 84027 | |
| GSK3B Fusion Protein Ag17320 | |
| Primary | |
| -20°C | |
| GSK3B |
| 0.41 mg/mL | |
| Polyclonal | |
| Liquid | |
| RUO | |
| PBS with 50% glycerol and 0.02% sodium azide; pH 7.3 | |
| GSK 3 beta, GSK3 beta, GSK3A B, GSK3B, GSK-3B, GSK3B 216P, gsk3beta | |
| Gsk3b | |
| IgG | |
| Antigen Affinity Chromatography | |
| Antibody |
Bitte geben Sie uns Ihr Feedback zu den Produktinhalten, indem Sie das folgende Formular ausfüllen.